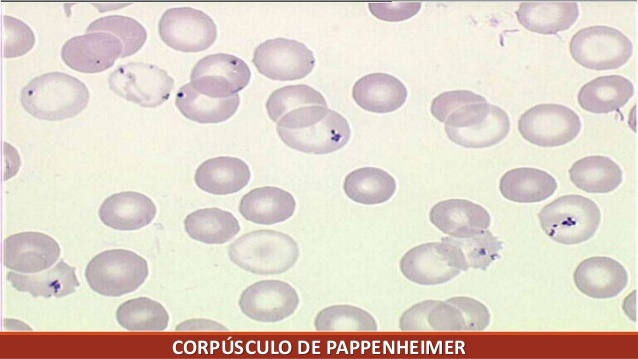

Como investigar as anemias inicialmente?
Reticulócitos
Hiperproliferativa (reticulocitose > 2%)
M.O. consegue responder a queda de Hb, produzindo mais eritroblastos pelo estimulo renal da eritropoetina, aumentando reticulocitos
Ex: anemia hemolítica, sangramento agudo
Hipoproliferativas (reticulócitos < 2%
M.O. não consegue responder ao aumento de demanda por hemáceas
Ex: Anemias carenciais, anemia de doença crônica, anemia sideroblástica
Quais os valores noramais de um hemograma completo?

Principais exemplos de…
Paciente com queixa de palidez cutâneo-mucosa, astenia, cefaleia, angina, inflamação da lingua, ferida no canto da boca, afundamento da unha, disfagia e avidez por comer gelo e terra…
Diagnóstico, principais achados clinicos e laboratoriais e conduta…
ANEMIA FERROPROVA
Sindrome anêmica: palidez cutâneo-mucosa, astenia, cefaleia, angina
Carência nutricional: glossite, queilite angular, coitoniquia, PICA (perversão do apetite, pagofagia), disfagia Plummer-Vinson
Laboratório:
Anemia normo/normo (inicio), micro/hipo (clássico), aumento de RDW, trobocitose reativa
Ferritina baixa
Transferrina, TIBC, receptor solúvel da transferrina aumentam
Ferro e saturação de transferrina baixam
Protoporfirina aumenta
Conduta: investigar causa
Sulfato ferroso 300mg (60mg Fe elementar) 3x/dia

Como se da o ciclo do ferro no organismo?
Não existe elminicação fisiológica do ferro, por isso sua absorção é ruim

Como está a ferritina, a transferrina, o TIBC (capacidade de ligação do ferro), o ferro sérico, saturação de transferrina e o RDW na anemia ferropriva?
Saturação de transferrina = ferro / TIBC
Se ferro cai, saturação tbm cai
RDW esta aumentado (anisocitose)

Principais causas de anemia ferropriva em crianças e em adultos…
Crianças: prematuridade, desmame precoce e ancilostomiase (eosinofilia)
Adultos: gravidez, hipermenorreia, sangramento GI crônico (> 50 anos: colono e EDA), má absorção (celíaca)
Como tratar anemia ferropriva? Como avaliar a resposta? Até quando tratar…
Sulfato ferroso
Dose: 300 mg (ou 60mg de Fe elementar) 3x/dia
Resposta: dosar reticulócitos (começam a aumentar com 3-4 dias, pico 7-10 dias)
Duração: 6 meses a 1 ano (repor estoque: ferritina) ou ferritina > 50ng/ml
Hb volta ao normal em 6-8 sem
Qual o exame padrão ouro para confirmar anemia ferropriva?
Biopsia de medula óssea com corante azul da prussia
Como acontece a anemia por doença crônica?
Infecção (TB…), inflamação (AR, LES, DII), neolpasias
Aumentam citocinas inflamatórias fazendo o figado liberar hepcidina, que aprisiona ferro no estoque (aumenta ferritina), diminuindo ação da transferrina e reduzindo absorção de ferro
Carência relativa de ferro
Tratamento: tratar causa de base
Como encontra-se o laboratório (perfil do ferro) na anemia de doença crônica?
Anemia normo/normo
Ferro sérico diminuido
Saturação de transferrina diminuida
Ferritina aumentada (ferropriva diminuida)
Transferrina, TIBC e receptor solúvel da transferrina diminuidos (ferropriva aumentada)
*Aumento de hepcidina no futuro (ferropriva diminuida)
Como acontece a anemia sideroblástica e principais causas? Perfil do ferro….
Falha na sintese do heme da Hb pro deficiência de protoporfirina
Causas: hereditária (micro/hipo), adiquirida (macro): alcool, chumbo, deficiência de B6 (tratamento de TB)
Aumenta o ferro sérico, pois ele não é utilizado na formação do heme, aumenta ferritina, e aumenta saturação de transferrina
Transferrina e TIBC normais
Ferro em escesso se deposita nos tecidos: risco de hemocromatose
Como diagosticar e tratar anemia sideroblástica…

Aspirado de M.O.: > 15% de sideroblastos em anel
Sangue periférico: acúmulo de corpúsculos de Pappenheimer
Tratamento: tratar causa de base (Alcool, chumbo), vitamina B6, dexferoxamina (quelante de ferro)
Como se encontra uma eletroforese de Hb normal e o que acontece nas talassemias?
4 Heme + 4 globinas = Hb
Eletroforese normal
HbA (97%): ææßß
HbA2 (2%): ææðð
HbF (1%): ææyy … domina até 6 meses
Beta-talassemia: defeito na quantidade de cadeias ß (HbA)
Alfa-talassemia: defeito na quantidade de cadeias æ (todas)
O que acontece na beta-talassemia e como se da o diagnóstico…
Defeito na quantidade de cadeias beta de globinas
Hemacea pequena e com sobra de cadeia alfa (tóxica)
Depois dos 6 meses de idade: predominio de HbF até essa idade (não tem cadeia beta)
Diagnóstico: eletroforese de Hb
Diminui HbA, aumenta HbA2, aumenta HbF (a que mais aumenta, mais facil de fazer)
Paciente com anemia hemolítica grave depois dos 6 meses de idade, icterícia, com hepatoesplenomegalia, baixa estatura, facies em esquilo e cranio em cabeleira, e hemocromatose…
Diagnóstico, laboratório, e tratamento
BETALASSEMIA MAJOR - COOLEY
Eletroforese de Hb: diminui HbA, aumenta HbA2 e HbF
Tratamento: ácido fólico, quelante do ferro, esplenectomia, transplante de M.O.

Diferencie os tres tipos de beta-talassemias
Beta-talassemia major: ß0ß0 ou ß0ß+
Ausência de beta-globulina, Anemia de Cooley, + grave, deformidades ósseas (facies em esquilo e cranio em cabeleira)
Tto: ácido fólico, quelante do ferro, esplenectomia, transplante MO
Beta-talassemia intermedia: ß+ß+
Clínica mais branda, apenas diminuição da produção de beta-globulina
Tto: ácido fólico e quelante do fero
Beta-talassemia minor: ß+ß, ß0ß
Traço beta-talassêmico
Acompanhamento
O que acontece na alfa-talassemia?
Defeito na quantidade de um ou mais genes alfa na cadeia de alfa de globinas
Hemacea pequena e com sobra de cadeia beta e gama (tóxica)
Sintomas so acontecem se 3 ou mais deleções, já ao nascimento pois HbF ja tem cadeia alfa
Quais as formas clinicas de alfa-talassemia…
Carreador assintomático (æ æ æ - )
Deleção de apenas uma cadeia
Alfa-talassemia minor (æ æ - - )
Só microcitose e hipocromia, Eletroforese de Hb normal
Alfa-talassemia intermedia (æ - - - )
Doença da HbH (junção das cadeias beta que sobram)
Anemia hemolítica moderada a grave
Eletroforese 5-40% de HbH
Hidropsia fetal (- - - -)
Incompatível com a vida
Eletroforese 80% de Hb Bart (junção de cadeias gama que sobram)
Como acontece a anemia megaloblástica, quais suas manifestações clinicas e laboratoriais…
Deficiência de ácido fólico e vitamina B12, bloqueando a sintese de DNA
Clínica: sindrome anêmica, glossite, queilite, diarreia (deficiência de B12 e ácido folico), sintomas neurológicos (def B12)
Laboratório: anemia macrocitica (>110), neutrofilos hipersegmentados (pleocitários), aumento de RDW, normocromia, pancitopenia leve, hemolise/eritropiese ineficaz (aumento de LDH e BI)

Causas de deficiência de ácido fólico? e de deficiência de B12?
Ácido fólico (folhas)
Vitamina B12 (proteinas animais)

Qual das anemias macrocíticas cursa com sintomas neurológicos e porque?
Deficiência de vitamina B12
Síndromes neurológicas (neuropatia, mielopatia, demência)
Vitamina B12 transforma ácido metilmanônico em succinil-CoA, substância que participa da formação da bainha de mielina
Como diferenciar anemia megaloblástica por deficiência de ácido fólico de vitamina B12? Como tratar cada causa…
Os dois causam:
Anemia macrocitica, neutrofilos hipersegmentados, aumento de RDW, normocromia, pancitopenia, hemolise, aumento de homocisteina
Só deficiência de B12:
Aumento do ácido metilmalônico
Deficiência de B12: repor B12 IM
Deficiência de ácido fólico: repor folato VO
Avaliar resposta com dosagem de reticulócitos
Qual a diferença de hemocaterese de hemólise?
Hemocaterese: destruição fisiológica de hemáceas senescentes pelos macrofagos do baço, media de 120 dias
Hemolise: destruição prematura e abrupta que acaba com as hemaceas antes que dê tempo para a medula compensar essa perda. Destruição de hemáceas jovens